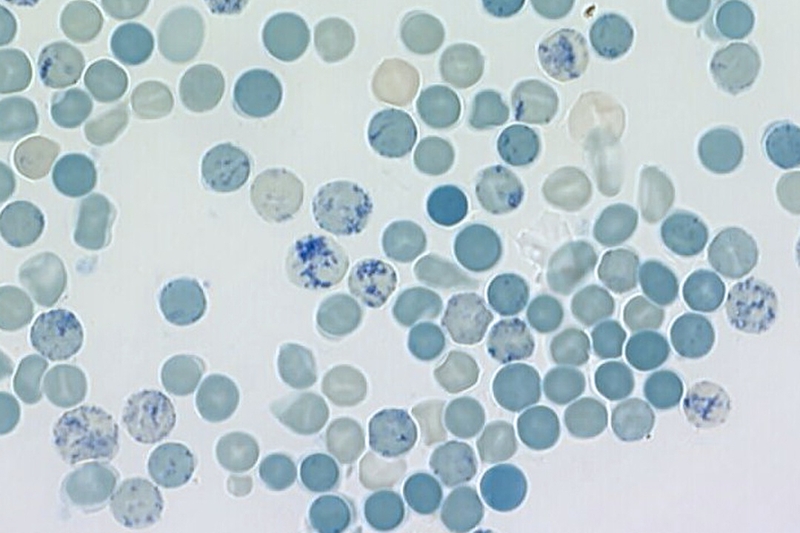
Xét nghiệm huyết đồ là gì? Vì sao phải làm xét nghiệm huyết đồ? 3

Tốt nghiệp đại học Khoa Dược. Có kinh nghiệm hơn 10 năm trong lĩnh vực Dược phẩm, tư vấn thuốc và thực phẩm chức năng. Hiện đang là giảng viên cho Dược sĩ tại Nhà thuốc Long Châu.
Thục Hiền
09/08/2024
Mặc định
Lớn hơn
Xét nghiệm huyết đồ là một trong những xét nghiệm huyết học quan trọng nhất và là phương pháp chẩn đoán y tế cần thiết trong việc đánh giá sức khỏe và xác định các vấn đề y tế tiềm ẩn. Qua việc phân tích các thành phần của mẫu máu, xét nghiệm huyết đồ cung cấp thông tin quan trọng về chức năng cơ bản của cơ thể và giúp phát hiện sớm các bệnh lý, bất thường hoặc tình trạng bệnh tiềm ẩn.
Bài viết này sẽ giúp bạn hiểu rõ hơn về ý nghĩa và quy trình của xét nghiệm huyết đồ, cùng những thông tin cần thiết để bạn có thể tận dụng công cụ này để bảo vệ sức khỏe của mình.
Xét nghiệm huyết đồ là một xét nghiệm y tế được sử dụng để đánh giá và phân tích các thành phần và thông số liên quan đến huyết học của bệnh nhân. Thông qua xét nghiệm huyết đồ, các chỉ số về công thức máu, hồng cầu lưới, bình luận các thông số khác như số lượng, hình thái, kích thước và tính chất bắt màu của các tế bào máu trong mẫu được đánh giá để đưa ra thông tin về tình trạng sức khỏe và phát hiện các bất thường liên quan đến huyết học.

Trong xét nghiệm huyết đồ, một mẫu máu được lấy từ bệnh nhân và được kiểm tra để xác định các thông số về công thức máu, hồng cầu lưới và bình luận về số lượng, hình thái, kích thước, tính chất bắt màu của tế bào máu.
Xét nghiệm công thức máu (Complete Blood Count with Differential) là một phần quan trọng của xét nghiệm huyết đồ (CBC). Nó bao gồm đánh giá số lượng và tỷ lệ phần trăm của các loại tế bào máu khác nhau có trong mẫu máu, bao gồm:
Xét nghiệm công thức máu cung cấp thông tin quan trọng về hệ thống máu và giúp phát hiện các bất thường và bệnh lý liên quan đến huyết học và hệ miễn dịch.

Xét nghiệm hồng cầu lưới (Reticulocyte Count) dùng để đánh giá tỷ lệ và số lượng hồng cầu lưới trong mẫu máu người bệnh. Hồng cầu lưới là hồng cầu trẻ chưa phát triển hoàn chỉnh.
Đo lượng hồng cầu lưới trong mẫu máu có thể cung cấp thông tin về tốc độ sản xuất hồng cầu mới trong cơ thể và chức năng tủy xương. Tăng số lượng hồng cầu lưới có thể cho thấy rằng cơ thể đang cố gắng tăng sản xuất hồng cầu để đáp ứng nhu cầu oxy của cơ thể. Các nguyên nhân gây tăng hồng cầu lưới bao gồm thiếu máu, suy giảm sản xuất hồng cầu, và mất máu.
Xét nghiệm hồng cầu lưới thường được sử dụng để đánh giá hiệu quả của liệu pháp điều trị thiếu máu, theo dõi tình trạng sản xuất hồng cầu sau phẫu thuật hoặc xử lý chế độ liều cao của thuốc chống ung thư. Nó cũng có thể được sử dụng để xác định nguyên nhân của thiếu máu hoặc đánh giá các bệnh lý liên quan đến hồng cầu.
Nội dung này áp dụng nguyên tắc quan sát các đặc điểm hình thái trên tiêu bản máu đã được nhuộm bằng Giemsa, rồi so sánh kết quả với các thông số đo lường và đếm được trên tiêu bản. Nếu có sự không tương thích giữa hai kết quả, cần xác định nguyên nhân do vấn đề kỹ thuật hay do sự tồn tại của bệnh lý. Điều này cho biết được sự biến đổi về số lượng hồng cầu, bạch cầu và tiểu cầu trong cơ thể, liệu chúng có tăng hay giảm so với mức bình thường. Ngoài ra, xét nghiệm huyết đồ cũng có thể phát hiện các dấu hiệu bất thường khác như sự hiện diện của ký sinh trùng gây sốt rét hoặc ấu trùng giun.
Xét nghiệm huyết đồ là một phương pháp quan trọng trong chẩn đoán và đánh giá tình trạng sức khỏe của một người. Dưới đây là một số lý do vì sao chúng ta cần thực hiện xét nghiệm huyết đồ:

Tóm lại, xét nghiệm huyết đồ là một công cụ quan trọng trong việc đánh giá sức khỏe và chẩn đoán các bệnh lý liên quan đến máu. Nó cung cấp thông tin quan trọng để xác định và theo dõi các vấn đề sức khỏe, từ đó giúp bác sĩ đưa ra chẩn đoán chính xác và lựa chọn phương pháp điều trị phù hợp.
Xem thêm:
Dược sĩ Đại họcNguyễn Thị Hồng Nhung
Tốt nghiệp đại học Khoa Dược. Có kinh nghiệm hơn 10 năm trong lĩnh vực Dược phẩm, tư vấn thuốc và thực phẩm chức năng. Hiện đang là giảng viên cho Dược sĩ tại Nhà thuốc Long Châu.